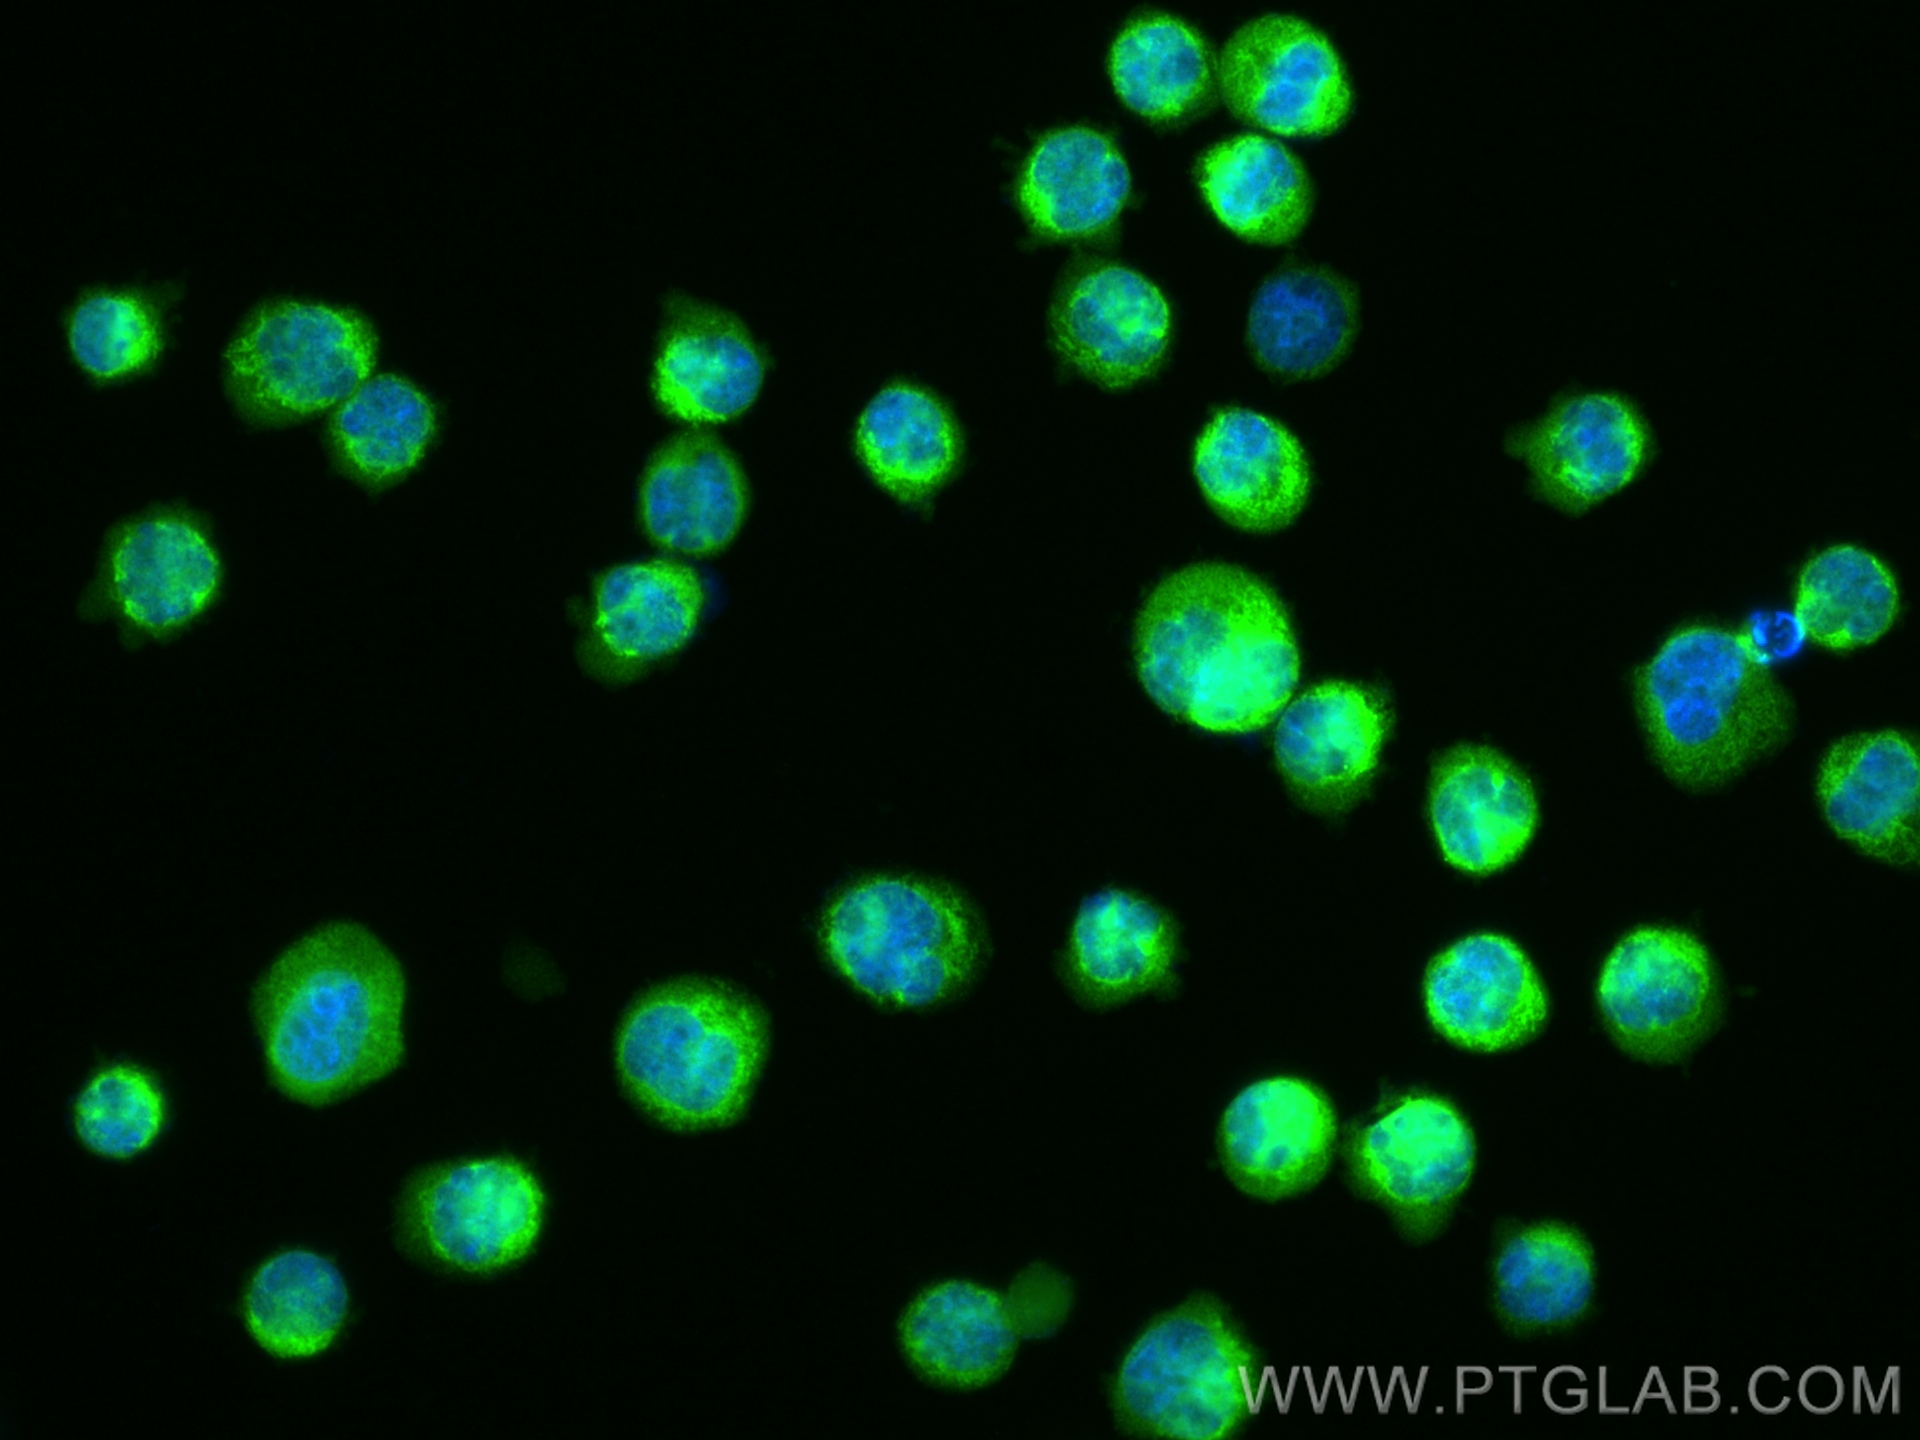

验证数据展示
经过测试的应用
| Positive WB detected in | Jurkat cells, HEK-293 cells, HepG2 cells, HeLa cells, NIH/3T3 cels, mouse testis tissue, rat testis tissue |
| Positive IP detected in | HeLa cells |
| Positive IHC detected in | mouse testis tissue, mouse colon tissue, rat colon tissue, rat testis tissue Note: suggested antigen retrieval with TE buffer pH 9.0; (*) Alternatively, antigen retrieval may be performed with citrate buffer pH 6.0 |
| Positive IF/ICC detected in | K-562 cells, HeLa cells |
推荐稀释比
| 应用 | 推荐稀释比 |
|---|---|
| Western Blot (WB) | WB : 1:5000-1:50000 |
| Immunoprecipitation (IP) | IP : 0.5-4.0 ug for 1.0-3.0 mg of total protein lysate |
| Immunohistochemistry (IHC) | IHC : 1:500-1:2000 |
| Immunofluorescence (IF)/ICC | IF/ICC : 1:200-1:800 |
| It is recommended that this reagent should be titrated in each testing system to obtain optimal results. | |
| Sample-dependent, Check data in validation data gallery. | |
产品信息
20954-1-AP targets DNMT3A in WB, IHC, IF/ICC, IP, ChIP, RIP, ELISA applications and shows reactivity with human, mouse, rat samples.
| 经测试应用 | WB, IHC, IF/ICC, IP, ELISA Application Description |
| 文献引用应用 | WB, IHC, IF, IP, ChIP, RIP |
| 经测试反应性 | human, mouse, rat |
| 文献引用反应性 | human, mouse, rat, goat |
| 免疫原 |
CatNo: Ag15111 Product name: Recombinant human DNMT3A protein Source: e coli.-derived, PGEX-4T Tag: GST Domain: 1-280 aa of BC043617 Sequence: MPAMPSSGPGDTSSSAAEREEDRKDGEEQEEPRGKEERQEPSTTARKVGRPGRKRKHPPVESGDTPKDPAVISKSPSMAQDSGASELLPNGDLEKRSEPQPEEGSPAGGQKGGAPAEGEGAAETLPEASRAVENGCCTPKEGRGAPAEAGKEQKETNIESMKMEGSRGRLRGGLGWESSLRQRPMPRLTFQAGDPYYISKRKRDEWLARWKREAEKKAKVIAGMNAVEENQGPGESQKVEEASPPAVQQPTDPASPTVATTPEPVGSDAGDKNATKAGDD 种属同源性预测 |
| 宿主/亚型 | Rabbit / IgG |
| 抗体类别 | Polyclonal |
| 产品类型 | Antibody |
| 全称 | DNA (cytosine-5-)-methyltransferase 3 alpha |
| 别名 | M.HsaIIIA, EC:2.1.1.37, EC:2.1.1.-, DNA MTase HsaIIIA, DNA (cytosine-5)-methyltransferase 3A |
| 计算分子量 | 912 aa, 102 kDa |
| 观测分子量 | 120-130 kDa |
| GenBank蛋白编号 | BC043617 |
| 基因名称 | DNMT3A |
| Gene ID (NCBI) | 1788 |
| RRID | AB_10733339 |
| 偶联类型 | Unconjugated |
| 形式 | Liquid |
| 纯化方式 | Antigen affinity purification |
| UNIPROT ID | Q9Y6K1 |
| 储存缓冲液 | PBS with 0.02% sodium azide and 50% glycerol, pH 7.3. |
| 储存条件 | Store at -20°C. Stable for one year after shipment. Aliquoting is unnecessary for -20oC storage. |
背景介绍
DNA methylation in vertebrate animals is an epigenetic modification that is important for embryonic development, imprinting, and the inactivation of X chromosomes. DNA methylation is catalyzed by a family of DNA methyltransferases (DNMTs) that include the maintenance enzyme DNMT1 and de novo methyltransferases DNMT3a and DNMT3b. The overexpression of DNMT1, DNMT3a, and DNMT3b has been reported in various malignancies, including gastric, urothelial, and lung cancers, and may be related to tumorigenesis, tumor progression, and poor survival. Two isoforms of DNMT3a exist: the full-length DNMT3a, and the shorter form DNMT3a2 which lacks the N-terminal fragment. DNMT3a is expressed ubiquitously at low levels, while DNMT3a2 is specially expressed at high levels in embryonic stem cells and shows restricted expression in tissues known to undergo de novo methylation including testis and ovary. This antibody was raised against the N-terminal region of human DNMT3a. It is expected to detect the 120-130 kDa DNMT3a but not 72-100 kDa DNMT3a2.
实验方案
| Product Specific Protocols | |
|---|---|
| IF protocol for DNMT3A antibody 20954-1-AP | Download protocol |
| IHC protocol for DNMT3A antibody 20954-1-AP | Download protocol |
| IP protocol for DNMT3A antibody 20954-1-AP | Download protocol |
| WB protocol for DNMT3A antibody 20954-1-AP | Download protocol |
| Standard Protocols | |
|---|---|
| Click here to view our Standard Protocols |
发表文章
| Species | Application | Title |
|---|---|---|
Mol Cancer CircNTNG1 inhibits renal cell carcinoma progression via HOXA5-mediated epigenetic silencing of Slug
| ||
J Hazard Mater GRP78/IRE1 and cGAS/STING pathway crosstalk through CHOP facilitates iodoacetic acid-mediated testosterone decline | ||
Protein Cell Epigenetic integrity of paternal imprints enhances the developmental potential of androgenetic haploid embryonic stem cells. | ||
Cell Mol Biol Lett miR-29b-3p regulates cardiomyocytes pyroptosis in CVB3-induced myocarditis through targeting DNMT3A | ||
Cell Biol Toxicol Hypermethylation of microRNA-497-3p contributes to progression of thyroid cancer through activation of PAK1/β-catenin. |